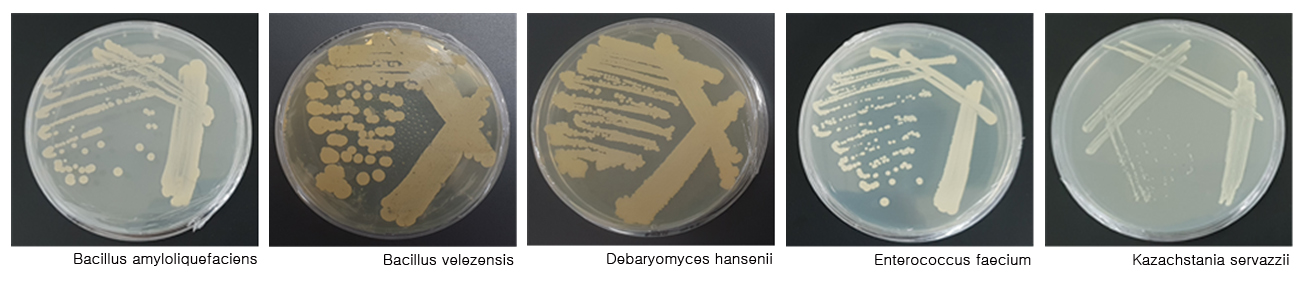

사진으로 보는 군정
-

- ‘원시반본과 후천의 성지 순창’출판기념식
- 구순(九旬)을 앞둔 순창의 향토사학자인 양상화씨가 순창을 생각하며 쓴 글을 모아 ‘원시반본과 후천의 성지 순창’을 출간했다. 30일 오전 10시 순창읍 한우마을 2층 궁전예식장에서 출판기념회를 갖고 저자의 강의도 함께 진행됐다. -2019년 5월 30-
- 담당부서 : 기획예산실
- 작성일 : 2019-06-11
-

- 미세먼지 취약계층 이용 공공시설 공기청정기 보급
- 순창군은 미세먼지 취약계층이 이용하는 공공시설 6곳에 공기청정기 65대 보급을 완료했다. 공기청정기는 보건의료원, 노인전문요양원, 노인복지관, 청소년수련관, 어린이장난감도서관, 건강증진센터 등 미세먼지에 취약한 계층이 주로 생활하고 활동하는 공간에 설치했다. -2019년 5월 30-
- 담당부서 : 기획예산실
- 작성일 : 2019-06-11
-
- 순창군친환경농업연구센터 기능성 미생물 발굴 성공
- 순창군농업기술센터(소장 설태송, 이하 센터)가 순창군 전통 발효식품 및 관내 토양에서 농작물 병해충 방제와 작물 생육 증진에 우수한 기능성 미생물을 발굴했다.센터가 확보한 미생물은 항균 활성을 가지는 바실러스 벨레젠시스(Bacillus velezensis), 바실러스 아밀로리퀴파시엔스(Bacillus amyloliquefaciens)다. 여기에 땅심증진 및 난분해성 유기물의 가용화가 뛰어난 효모균인 카자흐스타니아 세르바찌(Kazachstania servazzii), 데바리오미세스 한세니(Debaryomyceshansenii) 및 유산균인 엔테로코쿠스 페시움(Enterococcus faecium) 등 3가지를 더해 총 5가지다. -2019년 5월 30-
- 담당부서 : 기획예산실
- 작성일 : 2019-05-31
-

- 실내수영장, 유아 수상안전교육 시범운영
- 순창군이 실내수영장에서 유아기 물놀이 안전사고 예방을 위해 수상안전교육과 생존수영 프로그램을 시범 운영한다. 지난 4월말까지 관내 어린이집과 병설유치원을 대상으로 사전 접수를 거쳐, 최종적으로 팔덕어린이집 등 3곳에 총 30명이 이번 프로그램에 참여하게 됐다.지난 27일을 시작으로 오는 6월까지 기수별로 총 3회(1회 1시간씩)를 운영하며, 이용료는 유아 1명당 1,100원씩(1일 1회)을 받는다. -2019년 5월
- 담당부서 : 기획예산실
- 작성일 : 2019-05-31
-

- 희망하우스 빈집재생 프로젝트, 11동 지원
- 농촌지역에 방치된 빈집을 새롭게 단장해 인구감소에 주거환경 악화, 농촌마을 과소화 등 심각한 농촌문제를 해결하기 위한 방안으로 `희망하우스 빈집재생 프로젝트` 사업을 추진하고 있다. 방치된 빈집을 리모델링하여 귀농ㆍ귀촌인과 주거 취약계층 등에게는 주거공간으로, 지역예술가에게는 문화공간으로 5년 동안 무상 임대한다.또, 단순 주거형에서 지역내 문화네트워크 구축에 기여할 수 있는 지역예술가들이 비영리 운영조건이면 문화공간으로도 무상 임대도 가능해졌다. 문의 순창군 농촌개발과(063-1764) -2019년 5월 29 -
- 담당부서 : 기획예산실
- 작성일 : 2019-05-31
-

- ‘명랑시장’ 문화공연 성황
- 28일 저녁 7시 순창 향토회관에서 `문화가 있는 날`을 맞아 창작 뮤지컬 `명랑시장`공연이 군민 500여명이 참석해 성황을 이뤘다. `명랑시장`은 전통시장의 온기가 사라져가는 이 시대를 배경으로 주인공인 효녀 유정이가 시장에서 일하며, 시장사람들의 모습을 명랑하고 유쾌하게 그려낸 창작극이다. 6월에는 국악과 재즈를 접목한 창작국악인 송소희와 함께하는 ’국악, Jazz 樂 락‘ 공연을 준비하고 있다. -2019년 5월 28일-
- 담당부서 : 기획예산실
- 작성일 : 2019-05-31
-

- GCM 활용한 친환경 딸기, 블루베리 재배기술 세미나 개최
- 순창군이 최근 GCM 미생물 농법의 확산을 위해 관내 GCM 활용농가를 대상으로 친환경 딸기, 블루베리 재배기술 세미나를 개최했다. 이번 세미나는 전남대학교 친환경농업연구소와 공동으로 추진해, 전남대 김길용, 정우진 교수를 비롯, 연구원들도 강사로 나와 GCM 미생물 배양기술과 병해충 방제요령에 대한 교육을 진행했다. -2019년 5월 28 -
- 담당부서 : 기획예산실
- 작성일 : 2019-05-31
-

- 내달 4일관광두레사업 주민설명회 개최
- 순창군이 주민참여형 관광산업모델 구축을 위한 `관광두레사업` 주민설명회를 내달 4일 오후 4시에 순창어린이장난감도서관 2층에서 열린다.관광두레사업은 관(館) 주도형 관광개발사업에서 탈피해 주민의 자발적 참여와 지역자원의 연계를 통한 새로운 방식의 관광사업 모델을 구축하는 것에 목적을 두고 있다. -2019년 5월 28 -
- 담당부서 : 기획예산실
- 작성일 : 2019-05-31
-

- 순창 섬진강 적성들녘, 논그림 조성 계획
- 순창군이 섬진강 상류지역인 적성 괴정리 논을 한 폭의 캔버스 삼아 대형 그림을 완성할 예정이다.이에 논에 그림을 그리는 전문용역업체와 계약 체결을 완료하고, 그림 도안도 현대미술가의 도움을 받아 마무리했다. 그림 도안은 청정지역 순창을 나타내는 자연스러운 경관과 농촌지역의 평화로움을 그림에 담아냈다. -2019년 5월 28 -
- 담당부서 : 기획예산실
- 작성일 : 2019-05-31
-

- 가정의 달 장수사진·부부사진 촬영
- 풍산면 지역사회보장협의체(위원장 김동기)가 20일부터25일까지 무병장수를 기원하는 장수사진과 부부의 날 기념 부부사진 촬영 행사를 가졌다.이번 행사는 가정의 달을 맞아 경로의식을 고취하고 부부간의 사랑과 추억을 쌓을 수 있는 기회를 제공하기 위하여 장수사진이 없는 저소득 노인 5명을 선정해 장수사진을 촬영했다. 또 풍산면에 거주하는 부부 30쌍을 대상으로 부부사진 촬영도 함께 진행했다. 특히 순창읍 아름다운 사진관 윤지호 대표의 재능기부로 진행됐다. -2019년 5월 28 -
- 담당부서 : 기획예산실
- 작성일 : 2019-05-31